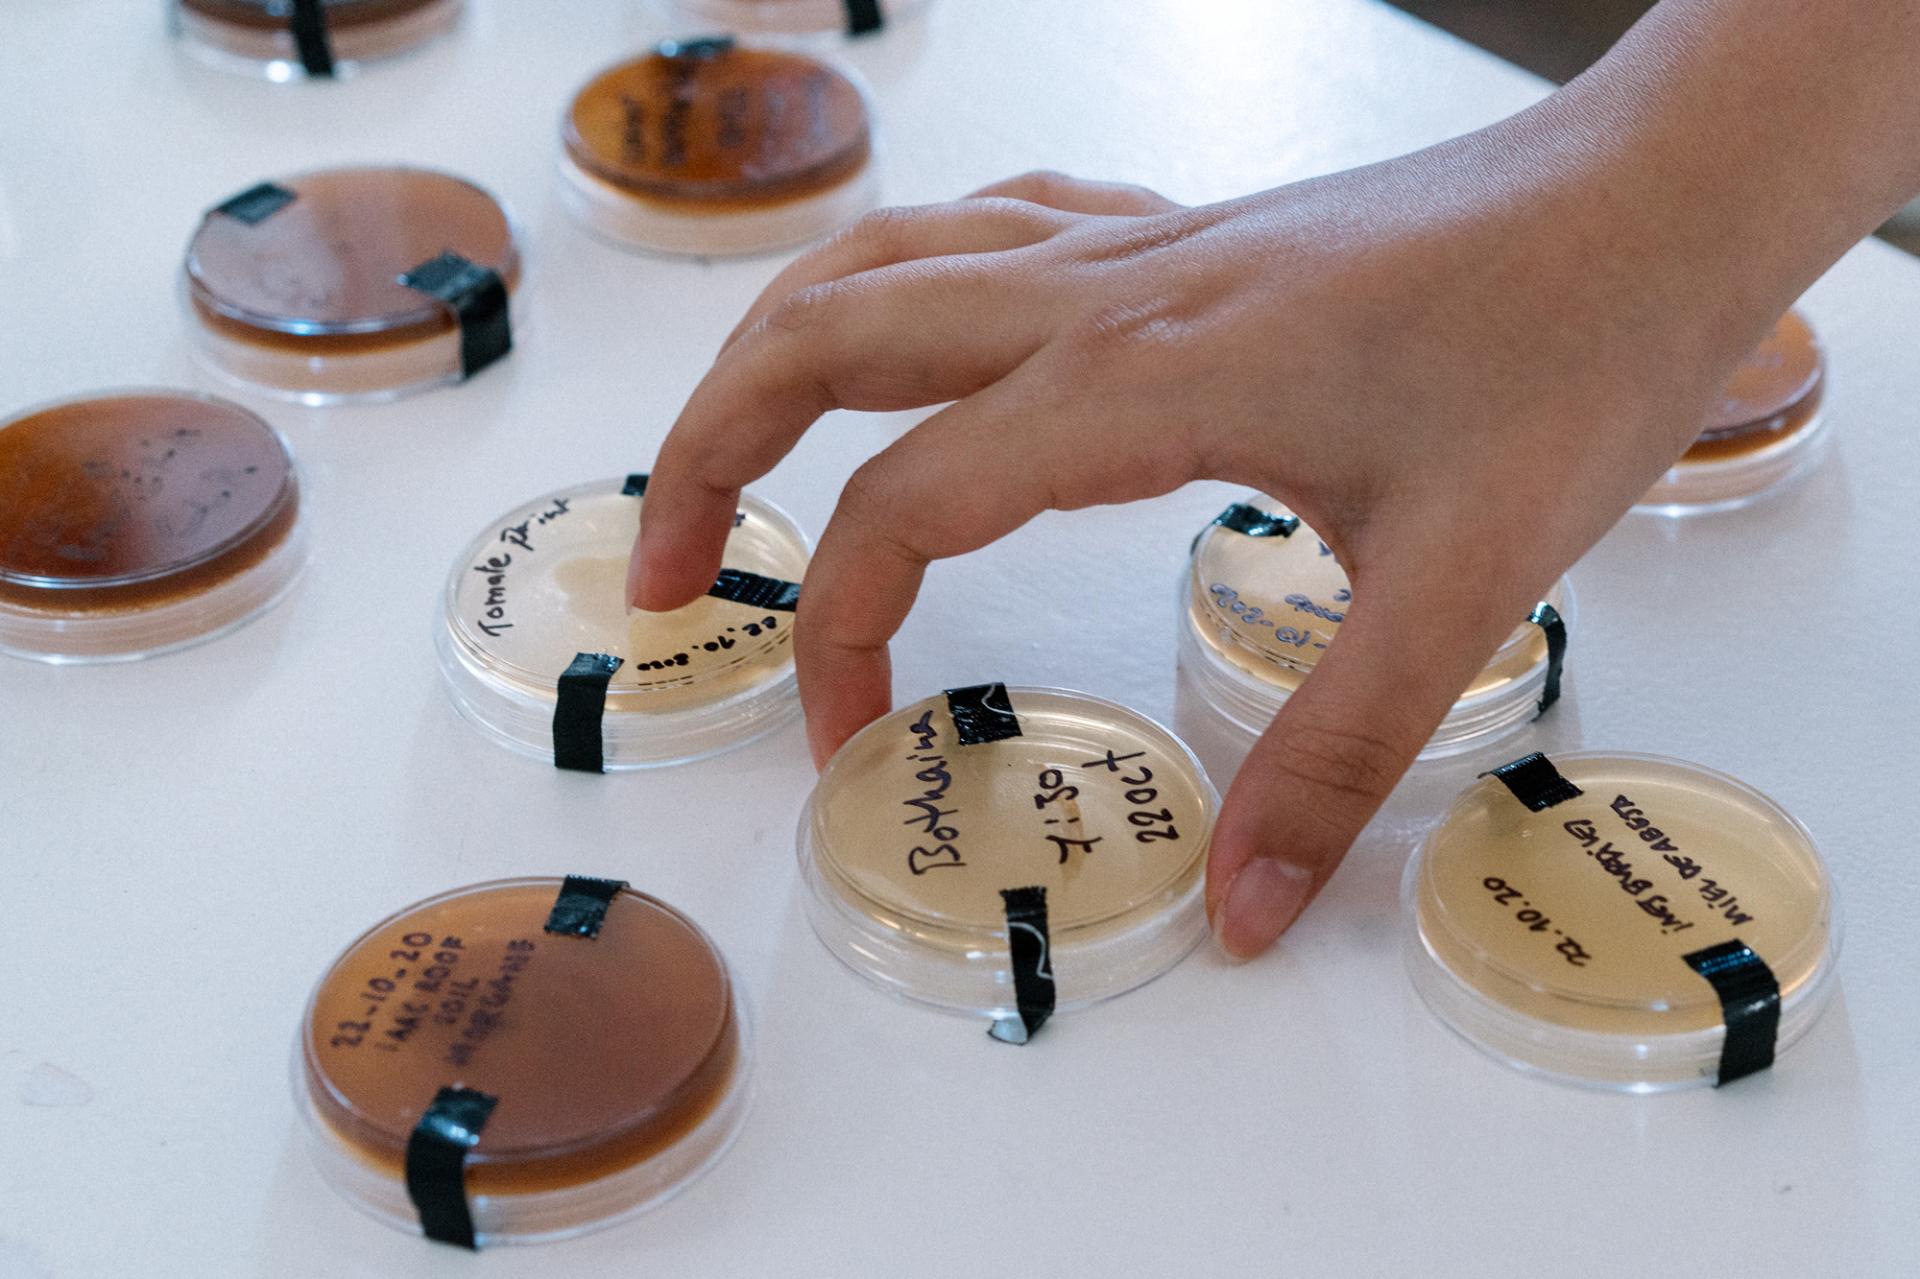

Design for Emergent Futures
Basic information
Project Title
Full project title
Category
Project Description
The Master in Design for Emergent Futures is a journey into designing for complexity, uncertainty and possibility. The futures we want tomorrow are enabled by the actions we take today. It is a multidisciplinary course which focuses on turning ideas into prototypes, platforms, actions and interventions to transform the current state of society. It is delivered by The Institute of Advanced Architecture of Catalonia, ELISAVA School of Design and Engineering, supported by Fab Lab Barcelona.
Project Region
EU Programme or fund
Description of the project
Summary
The Master in Design for Emergent Futures (MDEF) is a multidisciplinary course which focuses on turning ideas into prototypes, platforms, actions and interventions to transform the current state of society. On analysis of the current global state of affairs and societal challenges, students are encouraged to produce platforms, products and deployments that aim to respond to emergent futures. Our method is to propose small-scale interventions to approach large-scale challenges, in order to dissolve wicked problems, instead of solving them with single moonshot solutions.
The Master has four stages: Exploration, Instrumentation, Reflection and Application. These four steps provide designers with the strategic vision and tools to work at multiple scales in the real world. The theoretical and practical content in the program recognises and explores the possibilities of disruptive technologies: digital fabrication, blockchain, synthetic biology, Artificial Intelligence and others.
Students are encouraged to work at multiple scales (from bits to geography) in order to design and test interventions in the real world. At the same time, during the MDEF students will develop a hybrid profile that mixes various sets of skills (technical and human) that will be applied in the implementation of projects.
Key objectives for sustainability
The master is delivered in the context of the climatic crisis and responds to the need for designers, engineers and makers to practice design as a systemic process and collaborate across fields in order to innovate and develop new solutions. The course focuses on the Fab City model of prototyping in the city, working on multiple scales on intervention in order to develop situated design solutions that can be shared and replication through open design and knowledge transfer for the benefit of other locations, supported by the global Fab Lab and Fab City networks.
Key objectives for aesthetics and quality
MDEF is both a theoretical and practical program, that engages the expertise of Fab Lab Barcelona, IAAC and Elisava, Barcelona School of Design and Engineering It evolves the practice of design beyond objects, form-finding and pure speculation through a unique hands-on learning approach. Our method uses design processes to investigate complex systemic problems and proposes city-scale interventions to approach large-scale challenges. Students collaborate with multiple levels of stakeholders such as Space10 and industrial partners EcoAlf to develop user-centric outputs that also evolve the aesthetics of future-orientated design. This has been proven through students' engagement with biodesign to develop of new materials including from bacteria and alginates; the development of new hardware solutions including haptic electronic wearables; and new plastic surfaces designed through circular approaches to material waste such as recycling COVID masks into furniture.
Key objectives for inclusion
MDEF is built on an understanding of individual learning and personal development. It welcomes students from various professional backgrounds. Faculty aim to create a structured learning environment for students to apply their own interests and personalities to project-based learning. The Master favours collaboration and ‘human’ skills such as leadership, stakeholder management and teamwork. It is a safe space for students to explore their beliefs and craft their own ‘hybrid profile’ that mixes various sets of technical and human skills and prepares them to be resilient and agile designers to lead the new normal.
Results in relation to category
- To generate a new breed of ‘changemakers’ professionals in transdisciplinary fields combining high-tech, digital know-how and sustainable design strategies.
- To train professionals on new creative ways of using disruptive technologies to transform the industry.
- To prepare professionals to challenge the current productive model through emergent technological advances (digital fabrication, synthetic biology, artificial intelligence, blockchain, etc) and circular economy solutions.
- To train professionals in the development of projects with social, environmental and technological concerns.
- Be able to understand, develop, prototype and test new ideas on how design and technology are able to generate different outputs in any given reality.
- Acquire strong skills in the field of digital fabrication, synthetic biology, artificial intelligence, distributed ledger technologies and computer science.
- Be able to design and adopt new strategies to curb climate change in the product life cycle, design to accelerate economic transformation through a systems thinking approach and for social impact at the local scale through small interventions and sustainable initiatives.
- Be able to translate ideas into prototypes, and prototypes into products, which can be tested and iterated throughout the design process and be positioned within the market or design sector.
- Be able to recognize the potential of new business models associated to circular economy, self-sufficient paradigms and emergent technologies.
How Citizens benefit
The practical and theoretical aspects of the Master are combined to develop a portfolio of strategies, reflections and prototypes as well as a final project. Investigation is situated in the real world, often Barcelona city, where students can collaborate with local stakeholders to apply their knowledge to human centred needs. The final project is a ‘design intervention’, that is, a solution or response in the form of a product, platform or deployment. Working on hyperlocal interventions gives students a tangible design output that responds to a trend that is emerging at a global level and challenges the potential impact of technology in business, education, society and culture. Student interventions have ranged from urban environment health and wellness strategies to circular fashion systems.
Previous graduates of MDEF have proceeded to work in the subjects in which they specialised during the master. Specialist subjects ranged greatly – from understanding democratic governance and trust; questioning our food systems and how they will look in the future; new material development through synthetic biology; training fungi to consume chemical composites amongst many other varied topics facilitated by the unique environment created by the Master and Faculty.
Innovative character
Students develop their technical capabilities through the global Fab Academy program. This program equips students with working knowledge across the multiple disciplines of a Fab Lab from coding to digital fabrication. By the end of the Master students will be competent in a range of technical skills which they can apply to their final projects. At the same time, MDEF asks students to critically engage with the fields of speculation and foresight studies; they assess the role of disruptive technologies such as digital fabrication, blockchain, synthetic biology, Artificial Intelligence in the current transformation of society.